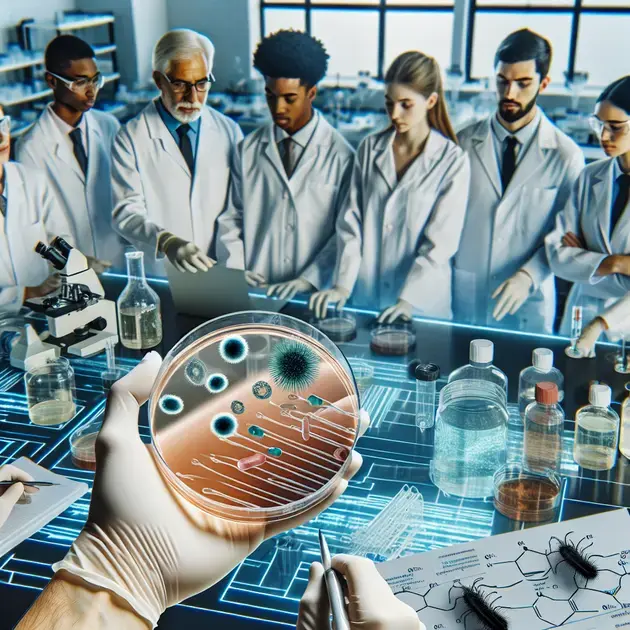
Simple lab-free test to detect bacteria in fluids from water to urine Simple lab-free test to detect bacteria in fluids from water to urine

This groundbreaking technology aims to overcome barriers in contamination detection by providing a simple and affordable solution that can be used by anyone. The biogel works by incorporating specialized molecular probes that react to the presence of bacteria, resulting in a color change that is easy to observe.
One of the key advantages of this biogel test is its versatility, as it can be adapted to detect a wide range of bacterial contaminants. This makes it applicable in various industries where fluid contamination is a concern, particularly in the food and medical sectors.
This biogel test offers a practical and efficient solution for quick and reliable contamination detection, potentially revolutionizing quality control processes in industries that require thorough testing. Its simplicity and cost-effectiveness also make it a valuable tool in developing regions or areas with limited access to advanced laboratory facilities.
In conclusion, the collaboration between engineers and biochemists has resulted in a biogel test that enables untrained users to easily detect fluid contamination. This innovative technology has the potential to greatly improve safety standards and promote widespread access to reliable testing methods.